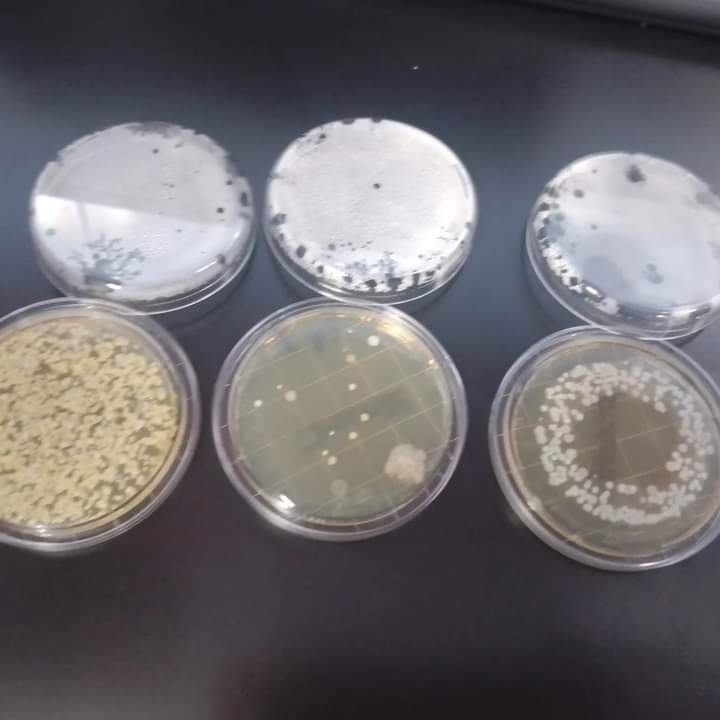
bacteriologicOF's tweet image. El uso de bata incorrecto EN TODO MOMENTO (lugares públicos,oficinas,etc) en 2022 Phinder y col. dieron a conocer el potencial riesgo que implica el portar la bata fuera de los lugares donde debe emplearse como EQUIPO DE PROTECCIÓN PERSONAL y no como uniforme de trabajo.
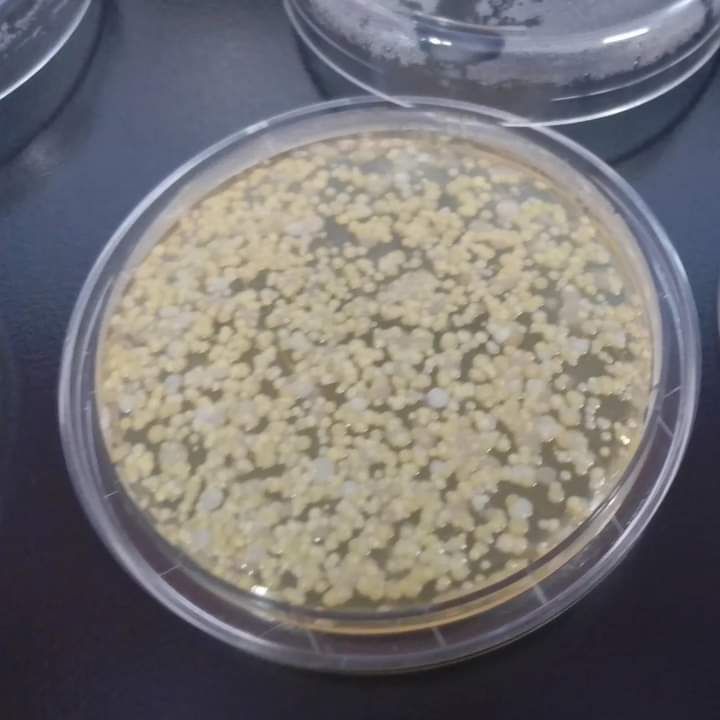
bacteriologicOF's tweet image. El uso de bata incorrecto EN TODO MOMENTO (lugares públicos,oficinas,etc) en 2022 Phinder y col. dieron a conocer el potencial riesgo que implica el portar la bata fuera de los lugares donde debe emplearse como EQUIPO DE PROTECCIÓN PERSONAL y no como uniforme de trabajo.

Don Infusorio Bacteriosaval
@bacteriologicOF
MVZ MSc hago un PhD pero me dicen muchacho #microbiología #biologíamolecular #biotecnología #FMVZUNAM #veterinaria #catlover Cazador de microbios🔬🧬💉
You might like
El uso de bata incorrecto EN TODO MOMENTO (lugares públicos,oficinas,etc) en 2022 Phinder y col. dieron a conocer el potencial riesgo que implica el portar la bata fuera de los lugares donde debe emplearse como EQUIPO DE PROTECCIÓN PERSONAL y no como uniforme de trabajo.

¿Cuál es tu plataforma favorita para buscar artículos científicos? Te presento una lista de las más importantes #hilo 🧵

Si hiciera un video o película de mis aventuras en el laboratorio, deberían tener filtro color sepia?
The flyer of our new book "Trending topics in Escherichia coli Research" is out. More information here or in our Latin American Coalition for #Escherichia coli Research (LACER) Facebook page: facebook.com/groups/2824952… or the LACER Twitter page:

United States Trends
- 1. Falcons 47,9 B posts
- 2. Rams 55,1 B posts
- 3. Stafford 38,6 B posts
- 4. Puka 21 B posts
- 5. Bijan 31 B posts
- 6. #WWERaw 48,8 B posts
- 7. Jared Verse 2.976 posts
- 8. Drake Maye 23,1 B posts
- 9. #GenshinMoonInvitation 1.641 posts
- 10. Xavier Watts 3.829 posts
- 11. #NewYearsAdviceFromTeyvat 1.627 posts
- 12. Raheem 4.262 posts
- 13. #LARvsATL 1.519 posts
- 14. Caleb Love 3.961 posts
- 15. DJ Humphries 1.451 posts
- 16. McVay 3.645 posts
- 17. mack 7.927 posts
- 18. #DirtyBirds 2.049 posts
- 19. Max Christie N/A
- 20. Blazers 3.044 posts
You might like
-
 Nata de Leche
Nata de Leche
@natz_firefly -
 Bioeticando
Bioeticando
@bioeticando -
 Poultry Vet
Poultry Vet
@PoulVetAnymore -
 Luis Hernández
Luis Hernández
@luisvet207 -
 Lili Rodríguez Ochoa
Lili Rodríguez Ochoa
@linchos -
 Olga Dominguez
Olga Dominguez
@olgadomm -
 Angel Crunch 🎱
Angel Crunch 🎱
@AngelRR_Crunch -
 Diccionario Montes
Diccionario Montes
@lobarroco -
 César Osorio
César Osorio
@CzarOz -
 ♡
♡
@LizBGL -
 dona ♡
dona ♡
@donuuuhh -
 Erick
Erick
@erick170216 -
 Majo M
Majo M
@MaJoseMX
Something went wrong.
Something went wrong.

































![kukuls_89's profile picture. [ Homo hominis lupus ]](https://pbs.twimg.com/profile_images/1023660848080797696/SlG-hWeH.jpg)












































